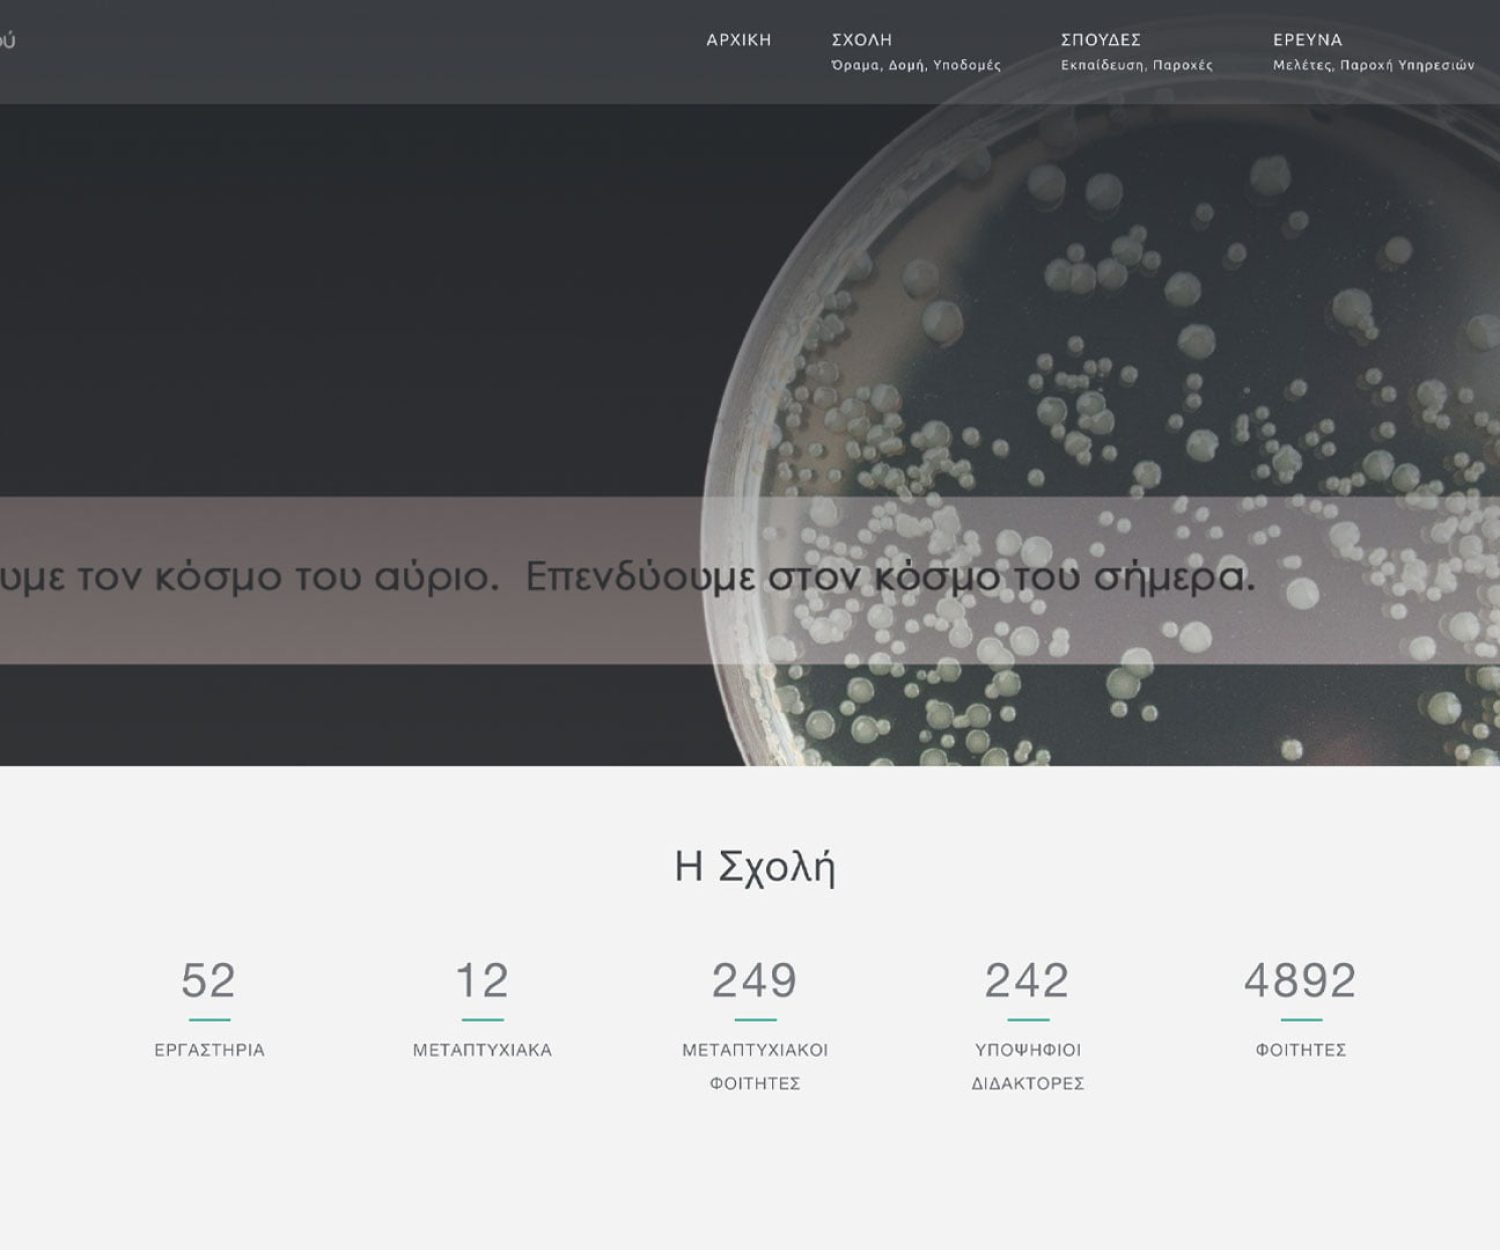
Κατασκευή Ιστοσελίδας - ΑΠΘ Σχολή Γεωπονίας Δασολογίας και Φυσικού Περιβάλλοντος -agrofor.auth.gr

ΚΑΤΑΣΚΕΥΗ ΙΣΤΟΣΕΛΙΔΑΣ
ΚΑΤΑΣΚΕΥΗ ESHOP
Digital Marketing
ΤΕΧΝΙΚΗ ΥΠΟΣΤΗΡΙΞΗ
Θεσσαλονίκη
Κατσαντώνη 32, Κορδελιό, 56334
+30 2313001930
+30 2313001930
Αθήνα
Πολυκράτους, Ακαδημία Πλάτωνος, 10442
+30 2104447852
+30 2104447852
Σέρρες
Πλ. Ελευθερίας 5, Ν. Σκοπός 62044
+30 2321321791
+30 2321321791